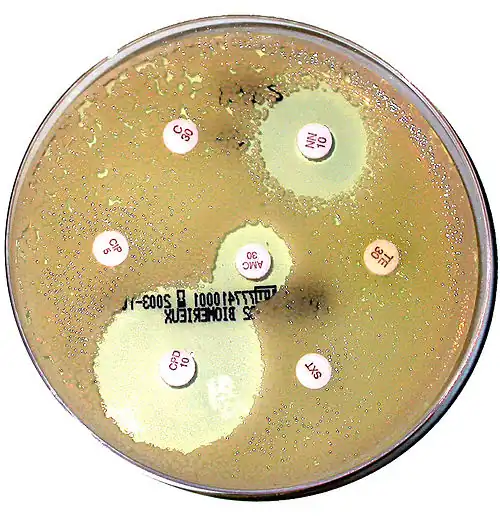

Antibiogramme
Un antibiogramme est une technique de laboratoire visant à tester la sensibilité d'une souche bactérienne vis-à-vis d'un ou plusieurs antibiotiques supposés ou connus.
Le principe consiste à placer la culture de bactéries en présence d’un ou des antibiotiques et à observer les conséquences sur le développement et la survie de celles-ci. On peut par exemple placer plusieurs pastilles imbibées d'antibiotiques sur une souche bactérienne déposée dans une boîte de Petri. Il existe trois types d'interprétation selon le diamètre de la zone d'inhibition qui entoure le disque d'antibiotique : bactérie sensible, intermédiaire ou résistante à l'antibiotique.
Réalisation d'un antibiogramme
Matériel
- Une gélose Mueller-Hinton en boîte de Petri
- Des disques d'antibiotiques, ou un distributeur permettant le dépôt standardisé des disques sur la gélose
- Une souche pure de la bactérie à étudier
- Un râteau ou un écouvillon
- Une pipette de 1 mL
- Un tube à hémolyse
- Une pipette Pasteur
- Un Étalon de Mac Farland 0.5 (1.5*10⁸ UFC/mL)
- De l'eau physiologique stérile
Étapes
Réalisation d'une suspension
Méthode 1 (si l'on dispose d'un bouillon de culture vieux de 24 h) :
- Pour les bactéries à Gram positif, effectuer une dilution au 1/500
- pour les bactéries à Gram négatif, effectuer une dilution au 1/5000
Méthode 2 (si l'on dispose de colonies pures sur un milieu de culture) :
- Mettre stérilement de l'eau physiologique dans un tube à hémolyse
- Prélever les colonies pures et les mettre en suspension jusqu'à obtenir la même opacité que l'étalon Mac Farland 0,5
- Si la suspension est trop trouble, ajuster l'opacité en ajoutant de l'eau physiologique
Préparation de la gélose
- Prendre la gélose de Mueller-Hinton, vérifier l'absence d'eau à la surface ; s'il y en a, laisser sécher
- Annoter où seront positionnés les disques d'antibiotiques sur le fond de la boîte (il faut les éloigner de 1 cm du bord minimum)
- Diviser la boîte autant de fois que vous avez d'antibiotiques (maximum 5 pour une boîte de 10 cm, ou 12 pour une boîte de 15 cm) ou utiliser un patron
- Ensemencer la gélose par 1 mL de suspension
- Étaler le volume avec le râteau du centre vers les bords ou tremper l'écouvillon dans la suspension, enlever l'excès d'inoculum par pression sur les bords du tube, écouvillonner régulièrement la gélose en tournant la plaque de 60° jusqu'à ensemencement de la totalité de la surface
- Laisser sécher de 3 à 5 minutes
- Déposer les disques d'antibiotiques
- Laisser incuber 24 h
Lecture des résultats
- Mesurer les diamètres des auréoles (zones d'inhibition de croissance de la souche microbienne)
Pour chaque souche microbienne, la sensibilité ou la résistance à un antibiotique est différente. Elle fait appel aux notions de concentration critique inférieure (c) et de concentration critique supérieure (C).
- c : dose minimale d'antibiotique qu'un malade peut recevoir sans dangers et qui fait effet sur la souche bactérienne.
- C : dose maximale d'antibiotique qu'un malade peut recevoir sans dangers et qui fait effet sur la souche bactérienne.
Pharmacocinétique : chez quelqu'un correctement traité par un antibiotique, la concentration d'antibiotique dans l'organisme est supposée osciller entre les concentrations critiques inférieure et supérieure.
Ces données sont disponibles sur des abaques.
Pour chaque couple bactérie-antibiotique, on détermine une concentration minimale inhibitrice (ou CMI). La CMI est la plus petite concentration d'antibiotique qui inhibe toute croissance visible. En comparant la CMI aux concentrations critiques, on détermine la sensibilité ou la résistance de la bactérie à l'antibiotique :
- La bactérie est sensible à l'antibiotique quand la CMI est inférieure à la concentration critique inférieure. Concrètement, ceci signifie qu'il suffit d'une faible concentration d'antibiotique pour tuer les bactéries et que cette dose nécessaire est encore plus faible que la plus faible des doses qu'on peut administrer chez l'homme. Si l'on traite quelqu'un avec l'antibiotique, la concentration de celui-ci dans l'organisme sera toujours suffisante pour tuer les bactéries.
- La bactérie est résistante à l'antibiotique quand la CMI est supérieure à la concentration critique supérieure. Concrètement, la dose nécessaire pour tuer les bactéries est bien trop élevée pour être supportée chez l'homme sans effets secondaires importants. Cet antibiotique ne peut pas être utilisé pour traiter une infection.
- La bactérie est sensible à l'antibiotique quand la CMI est comprise entre les deux concentrations critiques. En pratique, concentration est tantôt suffisante pour tuer les bactéries, tantôt insuffisante. Il faut considérer que la bactérie sera résistante in vivo et il ne faut pas utiliser cet antibiotique.
Lecture critique de l'antibiogramme
Un antibiogramme doit s'interpréter dans la mesure où les résultats in vitro ne sont pas toujours reproductibles in vivo. Par exemple, si un Staphylococcus aureus (Staphylocoque doré) est résistant à l'oxacilline (anciennement méticilline), il faut le considérer résistant à toutes les bêta-lactamines (toutes les pénicillines et toutes les céphalosporines deviennent inutilisables). On appelle une telle bactérie un SARM (Staphylococcus aureus résistant à la méticilline, MRSA en anglais).
L'utilisation de l'antibiogramme au quotidien
L'antibiogramme est un outil validé par un biologiste médical qui permet au médecin de choisir le bon antibiotique, ou l'association d'antibiotiques permettant de traiter efficacement un patient. Cependant, la plupart du temps, il n'est pas nécessaire car beaucoup d'infections sont traitées efficacement de façon probabiliste. On fait une hypothèse sur l'antibiotique et la bactérie à traiter en fonction du lieu de l'infection (amygdale, abdomen, poumon...) car ce sont souvent les mêmes espèces qu'on trouve aux mêmes endroits. Un antibiogramme est fait dans les cas d'infections graves (choc septique, infections nosocomiales...) ou lorsque les antibiotiques choisis en probabiliste ne fonctionnent pas. Cette attitude aboutit à l'utilisation répétée des mêmes antibiotiques et contribue à l'émergence de souches résistantes.
Du prélèvement à l'antibiogramme
On recueille les bactéries :
- Dans le sang (on fait alors une mises en culture, ou hémoculture)
- Dans les urines, les fientes
- Dans les selles, les excréments
- Dans les crachats, les lavages broncho-alvéolaires (on lave à l'eau les bronches pendant une fibroscopie et on analyse ce liquide de lavage)
- Dans le liquide céphalo-rachidien
Les bactéries sont mises en culture et ensuite identifiées : on détermine si c'est un staphylocoque, un streptocoque, etc. Ensuite, c'est le biologiste qui décide s'il est nécessaire de réaliser un antibiogramme.
La réalisation pratique de l'antibiogramme

L'antibiogramme est souvent automatisé. Les bactéries sont déposées en suspension (dans un liquide) dans un récipient, puis la machine aspire ce liquide et le dépose sur une carte (format carte de crédit) dans laquelle il y a de petites zones correspondant à chaque antibiotique. La machine lit ensuite cette carte et donne automatiquement les résultats (sensible, intermédiaire, résistant).
Parfois, on peut refaire un antibiogramme pour certains antibiotiques choisis par le biologiste. Soit on réalise la procédure décrite en 1. Soit on utilise d'autres techniques plus onéreuses, mais plus simples comme le E-test. On ensemence une boîte de Petri, puis on dépose une bande E-test qui comprend un gradient d'antibiotique croissant d'une extrémité à l'autre (pas d'antibiotique à gauche, concentration maximale à droite) et ces concentrations d'antibiotiques sont écrites directement sur cette bande. On met en incubation la boîte et on lit la CMI à l'intersection du disque d'inhibition avec la bande.
Interprétation de l'antibiogramme

- L'antibiogramme n'est pas rendu tel quel. Une interprétation des données brutes est nécessaire.
- Les résistances des bactéries ne s'expriment pas toujours. Il est donc important de connaître les résistances naturelles.
- Certaines résistances sont hétérogènes et ne vont toucher qu'une partie des souches. Dans ce cas, il est parfois nécessaire de travailler dans des conditions qui favorisent l'expression de la résistance.
- L'étude des mécanismes de résistance permet d'établir des profils de résistance.
- L'antibiogramme est également un bon outil d'orientation pour certaines souches difficiles à identifier.
Nomenclature
Les différents disque d'antibiotiques utilisés pour réaliser l'antibiogramme en phase solide sur gélose portent des abréviations, dont voici la liste:
| Code | Antibiotique |
|---|---|
| AM | Ampicilline |
| AMC | Amoxicilline + acide clavulanique |
| AMX | Amoxicilline |
| AN | Amikacine |
| ATM | Aztreonam |
| C | Chloramphénicol |
| CAZ | Ceftazidime |
| CD02 | Ceftazidime + Ac. Clavulanique 02 |
| CD03 | Ceftazidime + Ac. Clavulanique 03 |
| CF | Céfalotine |
| CIP | Ciprofloxacine |
| CPO | Cefpirome |
| CS | Colistine |
| CTX | Céfotaxime |
| CXM | Céfuroxime |
| E | Érythromycine |
| FA | Acide fusidique |
| FEP | Céfépime |
| FOS | Fosfomycine |
| FOX | Céfoxitine |
| FT | Nitrofurane-furane |
| GEN | Gentamicine 500 |
| GM | Gentamicine 500 |
| IMP | Imipénème |
| K | Kanamycine |
| KAN | Kanamycine 1000 |
| L | Lincomycine |
| LVX | Lévofloxacine |
| MA | Céfamandole |
| MOX | Moxalactame - Latamoxef |
| MXF | Moxifloxacine |
| N | Néomycine |
| NA | Acide Nalidixique |
| NOR | Norfloxacine |
| OFX | Ofloxacine |
| OX | Oxacilline |
| P | Pénicilline |
| PEF | Péfloxacine |
| PIP | Pipéracilline |
| PT | Pristinamycine |
| RA | Rifampicine |
| SPX | Sparfloxacine |
| SXT | Co-trimoxazole = Triméthoprime + Sulfaméthoxazol |
| TCC | Ticarcilline + Ac. Clavulanique |
| TE | Tétracycline |
| TEC | Teicoplanine |
| TIC | Ticarcilline |
| TM | Tobramycine |
| TZP | Pipéracilline + Tazobactam - Tazocilline |
| VA | Vancomycine |
Notes et références
Voir aussi
Articles connexes
- Portail de la microbiologie
- Portail de la médecine
- Portail de la pharmacie